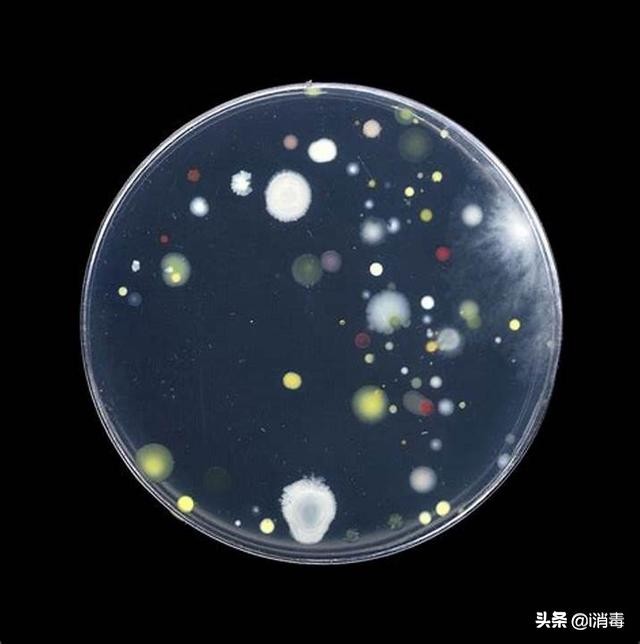
食品菌落总数超标的解决办法,食品企业大肠杆菌超标处罚

炎热的夏季,冰凉香甜的雪糕成了小孩的最爱,而今年上市的一款网红双黄蛋雪糕更是掀起了一股全网热潮,有趣的造型和独特的味道吸引了年轻人的目光,但是就在最近,这款全网爆红的网红雪糕出事了,网红双黄蛋雪糕被检测出大肠杆菌、菌落总数超标。

据温州市市场监督管理局发布夏令食品安全专项监督抽检通告,在夏令食品安全专项监督抽检中,“奥雪”牌双黄蛋(咸蛋黄牛奶味)雪糕被检出菌落总数、大肠菌群检出值不合格。

据调查介绍,抽查的这款“双黄蛋”雪糕菌落总数检出值(CFU/ mL)分别为:91000、96000、110000、110000、110000,不符合冰冻饮品国家食品安全标准的5次检验结果均不超过100000CFU/ml,且最高值超过25000CFU/mL小于100000CFU/mL的次数不超过2次的要求;大肠菌群检出值(CFU/mL)分别为:20、40、110、45、36,不符合5次检验结果均不超过100CFU/mL,且最高值超过10CFU/mL小于100CFU/mL的次数不超2次的要求。


无独有偶,早在2017年美国也发生大肠杆菌污染冰淇淋的事件,2017年八月美国食品药品管理局(FDA)发布召回公告,The Comfy Cow公司宣布召回10款冰激凌,因为产品受到大肠杆菌污染。据公告显示The Comfy Cow公司有几款冰激凌检出大肠杆菌或者大肠菌群超标。

大肠杆菌是人和动物体内存在数量最多的一种细菌,它主要生活在肠道内内,属于条件致病菌,大肠杆菌是评价食品卫生质量的重要指标之一,一旦食品中检测出大肠杆菌那么说明食品可能遭受到粪便的污染。运输和销售各环节,生产设备不干净、工人不注意卫生、杀菌设施、包装车间和销售环境差均可能导致大肠杆菌超标。

菌落总数是指在一定条件下(每克/每毫升)检样所生长出来的细菌菌落总数。一般反映食品在生产、储存、销售过程中的卫生措施和管理情况。利用菌落总数可预测食品的耐保存性。在中国和许多国家的食品卫生标准中,都有规定了各类食品菌落总数的标准。从卫生角度来说,超过了菌落总数标准,就会被列入卫生不合格产品。雪糕类产品此项超标,主要原因是灭菌不彻底或包材受污染,以及储存、运输污染。
冰淇淋雪糕菌落总数超标及大肠杆菌杆菌超标主要是因为以下几点:
1、原辅材料的污染:由于冰淇淋原料中含有奶制品、蛋制品、甜味剂、稳定剂及香精等,富含丰富的营养,非常容易受到微生物的侵蚀,加上不合理的贮存过程,会污染上一定的细菌,同时原料在贮运、加工过程中受到外来污染,大大增加了混合料中的细菌数。虽然经过高温杀菌,但不能完全将细菌,并且污染越严重,杀菌越困难,残留在混合原料中的细菌就多。

2、设备污染:由于雪糕冰淇淋加工过程中需要经过多道工序,再加上原料液较为粘稠,如牛乳、脱脂乳、炼乳、砂糖、乳粉、乳化剂等。并且加工中水环节比较多,又直接接触诸多加工设备,因此对加工所涉及的设备进行清洗、消毒不容忽视,就像美国某餐饮曾被爆出因冰淇淋机内部发霉的丑闻。混合物料经杀菌后与设备密切接触,如果消毒不彻底,将可能造成产品微生物超标。

3、人员,车间空气的污染:加工人员的卫生也是很重要的一环,生产加工人员进入车间时工作服手套消毒不彻底,或者不按卫生要求操作,都会直接或者间接的污染加工的雪糕冰淇淋。车间空气中的细菌,雪糕中的菌落总数也随着空气中细菌的增多而增加,经相关分析,二者相关非常显著,随着生产时间的延长,车间空气污染也会逐渐加重,所以要定期保证对生产车间空气进行灭菌处理。

4、包装、运输环节的污染:冰淇淋雪糕等包装材料都比较简单,直接与产品接触,再加上冰淇淋雪糕可能经过融化产生水分,易受细菌污染,所以包装材料要进行严格的消毒杀菌,同时也要确保运输过程的卫生安全。
专家建议:
雪糕冰淇淋生产加工中,要避免大肠杆菌、菌落总数超标。可使用过氧化氢复配银离子灭菌产品,能高效杀大肠杆菌,特点是作用快而强,能杀死所有病原微生物,应用广泛。可作食品灭菌剂,且没有抗药性,是一种新型的安全、高效、广谱消毒剂,无“三致效应”,是联合国卫生组织*级A**消毒产品,以比利时(诺福)为代表。
诺福可对车间的空气、设备、包装、工器具、内建筑物(如地面、墙壁、天花板)消毒杀菌。在冰淇淋、雪糕生产过程中,冰淇淋、雪糕很容易被生产车间的空气、设备、工器具、内建筑物(如地面、墙壁、天花板)上的微生物所污染,之后出现菌落总数超标问题。所以,减少甚至消除这些物品和场所的微生物数量,是减少冰淇淋产品中的微生物含量、避免菌落总数超标、提高冰淇淋食品安全的最有效的方法。

诺福安全环保,完全生物可分解,对人体无害,无腐蚀性,无残留。并且无色,无气味,无味道,不起沫,完全溶于水,使用安全,可高效杀灭雪糕冰淇淋中的大肠杆菌,同时对酵母菌,霉菌等致病菌都有着很强的杀灭效果,诺福可以再0-95°的情况下使用,效果极其稳定。
诺福冷杀菌产品应用广泛,产品来自欧洲最负盛名的食品消毒领军企业--比利时ic集团,诺福在欧洲多年的科学研究以及实战经验,有着一套完整的食品领域灭菌技术,目前已经进入中国十年时间,可根据企业的不同特性量身打造最完美的灭菌服务方案,更多灭菌方案请搜索润联高工。